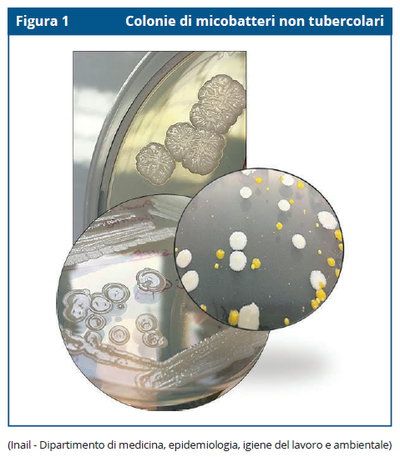

Per utilizzare questa funzionalità di condivisione sui social network è necessario accettare i cookie della categoria 'Marketing'.
Inail: i rischi di esposizione a micobatteri non tubercolari
Roma, 1 Mar – Nell’Allegato XLVI del D.Lgs. 81/2008 e s.m.i., contenente l’Elenco degli agenti biologici classificati, sono presenti i micobatteri non tubercolari, classificati nel 2° gruppo di rischio. E la trasmissione dei micobatteri dall’ambiente all’uomo, al di là dell’ipotesi di una “trasmissione interumana della malattia non ancora sufficientemente documentata”, avviene per via aerea “a seguito dell’inalazione di aerosol (particelle liquide o solide aerodisperse) contaminato dal microrganismo presente in composti per giardinaggio, terriccio, bacini idrici naturali, impianti distribuzione acqua, soffioni doccia, umidificatori, vasche idromassaggio, serbatoi, ecc”.
A soffermarsi sui micobatteri non tubercolari e sui rischi connessi è un recente factsheet prodotto dal Dipartimento Inail di medicina, epidemiologia, igiene del lavoro e ambientale (DIMEILA).
Il factsheet “Rischio di esposizione a micobatteri non tubercolari in ambienti di vita e di lavoro” ricorda che il genere Mycobacterium “è costituito da un gruppo eterogeneo di specie e sottospecie batteriche. Ad eccezione del Mycobacterium tuberculosis complex, del Mycobacterium leprae complex e di Mycobacterium ulcerans, le rimanenti specie sono complessivamente indicate come ‘micobatteri non tubercolari’ (Non Tuberculous Mycobacteria, NTM).
Si indica poi che i NTM comprendono “oltre 190 specie e sottospecie ambientali di cui un numero limitato sono patogene per l’uomo”. E che “negli ultimi due decenni, nei Paesi ad elevato livello socio-economico, si è assistito ad un incremento della prevalenza e dei tassi di incidenza delle infezioni causate da NTM non soltanto in persone con patologie preesistenti ma anche in individui sani”. Si ritiene poi che l’aumento dei casi “possa essere attribuito a numerosi fattori tra cui la maggiore disponibilità di tecniche microbiologiche più sensibili e specifiche rispetto al passato, l’aumento del rischio di esposizione e l’ invecchiamento della popolazione”.
L’articolo di presentazione del factsheet si sofferma sui seguenti argomenti:
- Micobatteri non tubercolari: quali sono le conseguenze sulla salute?
- Micobatteri non tubercolari: incidenza della malattia e rischi occupazionali
- Micobatteri non tubercolari: ci sono misure di prevenzione?
Micobatteri non tubercolari: quali sono le conseguenze sulla salute?
Il factsheet - a cura di A. Mansi, I. Amori, A. M. Marcelloni, A. R. Proietto, B. M. Rondinone, P. Tomao - ricorda che anche laddove avvenga una trasmissione dei micobatteri all’uomo “la maggior parte delle persone in buono stato di salute non sviluppa patologia”.
Riprendiamo dal documento una immagine relativa ai NTM:
Tuttavia negli individui con patologie polmonari croniche, “l’esposizione a fonti ambientali contaminate da micobatteri non tubercolari potrebbe invece indurre lo sviluppo di una malattia polmonare rara chiamata ‘malattia polmonare da micobatteri non tubercolari’ (NTM lung Disease, NTM-LD)” che insorge “soprattutto in individui con malattie preesistenti a carico dell’apparato polmonare quali ad esempio bronchiectasie, broncopneumopatia cronica ostruttiva (BPCO) e fibrosi cistica, ma a volte interessa anche persone che non presentano comorbilità”.
Questa è una patologia cronica e debilitante “che porta ad una diminuzione della funzionalità polmonare. La diagnosi precoce della NTM-LD è importante per la gestione della malattia ma spesso risulta complicata a causa della sintomatologia aspecifica o sovrapposta in pazienti con malattia polmonare sottostante. I sintomi più comuni sono rappresentati da tosse con produzione di espettorato, tosse con sangue (emottisi), febbre, perdita di peso, stanchezza”.
Si indica poi che la ‘malattia extra-polmonare da micobatteri non tubercolari’ è un’altra “forma clinica che si manifesta in pazienti immunodepressi a seguito di infezioni della cute e dei tessuti molli causate dall’utilizzo di dispositivi medici (cateteri, endoscopi, broncoscopi) contaminati da alcune specie di micobatteri non tubercolari (MAC, M. fortuitum, M. abscessus e M. chelonae)”.
Micobatteri non tubercolari: incidenza della malattia e rischi occupazionali
Il documento segnala che in Italia la malattia polmonare da micobatteri non tubercolari “è soggetta a notifica in classe III (d.m. 15/12/1990) ma l’incidenza della malattia è ampiamente sottostimata a causa della complessità della diagnosi che richiede un approccio multidisciplinare coinvolgendo diverse professionalità sanitarie tra cui pneumologi, infettivologi, radiologi e microbiologi”. E la gestione laboratoristica dei campioni clinici “è complessa perché questi batteri hanno lunghi tempi di crescita (da una a più settimane) e inoltre la presenza di molte specie tra loro diverse rende difficile la corretta identificazione del batterio responsabile dell’infezione”.
Si indica poi che i principali fattori di rischio per l’acquisizione dell’infezione “sono rappresentati dalla suscettibilità dell’ospite (malattie preesistenti a carico dell’apparato polmonare, comorbilità, immunodepressione), presenza di fattori di virulenza propri della specie batterica ed esposizione a fonti ambientali contaminate”.
Riguardo a queste fonti, come già parzialmente indicato in premessa, “i micobatteri non tubercolari sono presenti in acque naturali, terriccio, polvere ma anche all’interno di serbatoi artificiali (impianti distribuzione acqua, umidificatori, macchine per il ghiaccio, nebulizzatori, unità di riscaldamento-raffreddamento, ecc.) da cui è difficile eradicarli a causa di alcune peculiarità (parete cellulare idrofobica e produzione di biofilm) che conferiscono al batterio resistenza nei confronti dei comuni trattamenti di disinfezione dell’acqua”.
Vari studi hanno poi documentato casi di NTM-LD verificatisi “a seguito dell’inalazione di aerosol contaminato durante lo svolgimento di attività quotidiane quali ad esempio il giardinaggio, uso di doccia e vasche idromassaggio, ecc”. E in ambito occupazionale, “patologie riconducibili a questi batteri sono state accertate in lavoratori (giardinieri, agricoltori, addetti impianti depurazione, geologi, operai industrie automobilistiche, settore siderurgico, lavorazione dell’industria del vetro e metallo, ecc.) esposti a fonti ambientali contaminate”.
In particolare “casi di polmoniti da ipersensibilità in lavoratori in buono stato di salute sono stati associati ad alcune specie di NTM” isolate “da fluidi (emulsionanti, oli da taglio) per la lavorazione di metalli (Metal Working Fluid, MWF) impiegati per la produzione di componenti per l’industria automobilistica o aerospaziale”.
Micobatteri non tubercolari: ci sono misure di prevenzione?
Riguardo infine alle misure di prevenzione, si sottolinea che, nonostante le evidenze scientifiche, “il rischio di esposizione a NTM è ancora poco conosciuto essendo ancora limitate le conoscenze sui principali fattori di rischio che possono essere associati alla malattia polmonare da NTM”.
Inoltre – continua il documento – “non essendo al momento disponibili protocolli standardizzati per il campionamento e l’analisi di NTM in matrici ambientali nonché indicazioni riguardo idonee misure di prevenzione e protezione, la valutazione e il controllo del rischio di esposizione a questi batteri risulta di difficile attuazione negli ambienti di vita e di lavoro”.
Ricordando poi che la NTM-LD sopraggiunge su patologie respiratorie già presenti (bronchiectasie, BPCO, pneumoconiosi, tubercolosi), “la diagnosi precoce di queste malattie è fondamentale” per prevenirla. E si raccomanda, quindi, di “consultare sempre il proprio medico in caso di sintomi riconducibili ad una infiammazione delle vie aeree associata a tosse cronica produttiva, rinosinusite, dispnea, febbre o astenia che non si risolvono entro due settimane. È importante seguire con attenzione la prescrizione del medico ed informarlo se i sintomi respiratori non migliorano o se compaiono complicazioni”.
RTM
Scarica il documento da cui è tratto l'articolo:
Inail, Dipartimento di medicina, epidemiologia, igiene del lavoro e ambientale, “ Rischio di esposizione a micobatteri non tubercolari in ambienti di vita e di lavoro” a cura di A. Mansi, I. Amori, A. M. Marcelloni, A. R. Proietto, B. M. Rondinone, P. Tomao, Factsheet edizione 2022 (formato PDF, 717 kB).
Vai all’area riservata agli abbonati dedicata a “ Rischio biologico: l’esposizione ai micobatteri non tubercolari”.
I contenuti presenti sul sito PuntoSicuro non possono essere utilizzati al fine di addestrare sistemi di intelligenza artificiale.
Per visualizzare questo banner informativo è necessario accettare i cookie della categoria 'Marketing'
